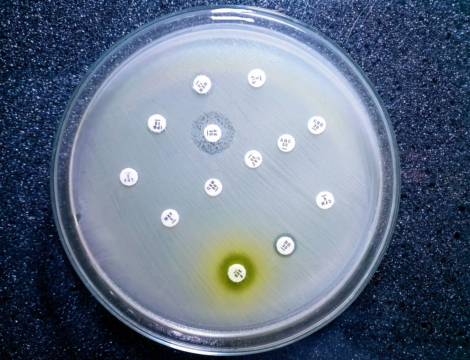
L’OMS alerte sur une résistance mondiale croissante aux antibiotiques

- Accueil ›
- Thérapeutique
Thérapeutique
Des nouveaux médicaments à la dermocosmétique, tous les produits que vous délivrez au quotidien
Médicaments Tout sur Médicaments




Publicité
Produits Tout sur Produits


Vigilances Tout sur Vigilances

Publicité
Publicité
- Comptoir officinal : optimiser l’espace sans sacrifier la relation patient
- Reishi, shiitaké, maitaké : la poussée des champignons médicinaux
- Budget de la sécu 2026 : quelles mesures concernent les pharmaciens ?
- Cancers féminins : des voies de traitements prometteuses
- Vitamine A Blache 15 000 UI/g : un remplaçant pour Vitamine A Dulcis




